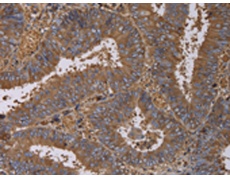
一抗

|
Background: |
The protein encoded by this gene is a member of the fatty acid desaturase (FADS) gene family. Desaturase enzymes regulate unsaturation of fatty acids through the introduction of double bonds between defined carbons of the fatty acyl chain. FADS family members are considered fusion products composed of an N-terminal cytochrome b5-like domain and a C-terminal multiple membrane-spanning desaturase portion, both of which are characterized by conserved histidine motifs. This gene is clustered with family members FADS1 and FADS2 at 11q12-q13.1; this cluster is thought to have arisen evolutionarily from gene duplication based on its similar exon/intron organization. |
|
Applications: |
ELISA, WB, IHC |
|
Name of antibody: |
FADS1 |
|
Immunogen: |
Fusion protein of human FADS1 |
|
Full name: |
fatty acid desaturase 1 |
|
Synonyms: |
D5D; TU12; FADS6; FADSD5; LLCDL1 |
|
SwissProt: |
O60427 |
|
ELISA Recommended dilution: |
2000-5000 |
|
IHC positive control: |
Human colon cancer and human thyroid cancer |
|
IHC Recommend dilution: |
100-300 |
|
WB Predicted band size: |
52 kDa |
|
WB Positive control: |
Human fetal brain tissue |
|
WB Recommended dilution: |
500-2000 |


 購(gòu)物車
購(gòu)物車 幫助
幫助
 021-54845833/15800441009
021-54845833/15800441009